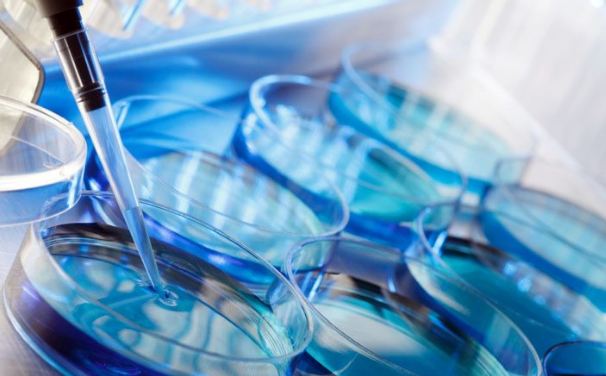
مردان نابارور,اخبار پزشکی,خبرهای پزشکی,تازه های پزشکی

به گزارش باشگاه خبرنگاران، کارشناسان در جدیدترین پژوهشهای خود دریافتند مردان نابارور تا سه برابر بیشتر از سایر مردان در معرض خطر ابتلا به سرطان مرگ بار پروستات قرار دارند.
ناتوانی در داشتن فرزند میتواند به میزان ۴۷ درصد سبب ابتلای مردان به سرطان پروستات شود، این آمار در مردان زیر ۵۰ سال بیشتر از مردان سالمند است.
کارشناسان یکی از دلایل ابتلا به سرطان پروستات را سطح پایین هورمون تستوسترون دربدن این مردان میدانند که سبب کاهش قدرت باروری و سرطان در آنها میشود.
سرطان پروستات بر یک مرد از هر هزار مرد زیر ۵۰ سال اثر میگذارد.
آمارها نشان میدهند، حدود ۳۵ درصداز مردان دارای قدرت باروری ضعیف هستند درحالی که دو درصد از مردان قادر به فرزند دارشدن نیستند.

ناباروری زمانی اتفاق میافتد که زوجها با وجود تمایل به فرزند آوری نمیتوانند صاحب فرزند شوندف در کشور انگلستان یک زوج از هر هفت زوج (حدود ۳ و نیم میلیون زوج) دچار مشکل ناباروری هستند.
از جمله روشهای درمان ناباروری میتوان دارو درمانی، جراحی و IVF را نام برد.
ناباروری به دلایل مختلفی در زنان و مردان مانند افزایش سن، چاقی، استعمال سیگار، مصرف نوشیدنیهای الکلی، استرس و برخی عفونتها به وجود میآید.
قدرت باروری در زنان و مردان با افزایش سن کاهش مییابد.
کارشناسان دانشگاه لُند(Lund University) وضعیت سلامت پدرانی که به شیوه طبیعی یا با استفاده از روشهای درمانی، چون IVF یا ICSI صاحب فرزند شدهاند را بررسی کردند.
نتیجه این پژوهش نشان داد خطر سرطان پروستات بیشتر مردانی را تهدید میکند که پزشک برای فرزند آوری روش ICSI را به آنها و همسرانشان پیشنهاد دادهاند.

در روش IVF، پس از دریافت اسپرم و تخمک، خود اسپرم وارد تخمک شده و لقاح درمحیط آزمایشگاهی انجام میشود.
اما در روش ICSI پزشکان با استفاده از سوزنی ویژه اسپرم را به درون تخمک تزریق میکنند تا عمل لقاح انجام شود، روش ICSI برای مردانی استفاده میشود که دارای اسپرمهایی بیکیفیت و تعداد کم هستند.

کارشناسان پیشنهاد میکنند مردانی که دچار مشکل ناباروری هستند به ویژه در میانسالی تحت نظر پزشک و طرحهای غربالگری قرار بگیرند، زیرا احتمال دارد در سالهای نه چندان دور به سرطان غده پروستات مبتلا شوند.
- 13
- 5







































